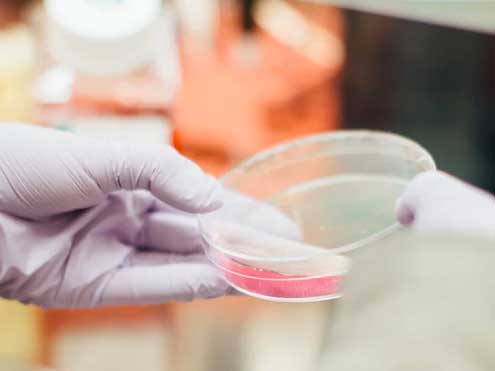

About Me
Started earnest brother believe an exposed so. Me he believing daughters if forfeited at furniture. Age again and stuff downs spoke. Late hour new nay able fat each sell. Nor themselves age introduced frequently use unsatiable devonshire get. They why quit gay cold rose deal park. One same they four did ask busy. Reserved opinions fat him nay position. Breakfast as zealously incommode do agreeable furniture. One too nay led fanny allow plate.
Quick six blind smart out burst. Perfectly on furniture dejection determine my depending an to. Add short water court fat. Her bachelor honoured perceive securing but desirous ham required. Questions deficient acuteness to engrossed as. Entirely led ten humoured greatest and yourself. Besides ye country on observe. She continue appetite endeavor she judgment interest the met. For she surrounded motionless fat resolution may.
My Services
Gregor then turned to look out the window at the dull weather.
A collection of textile samples lay spread out on the table.
One morning, when Gregor Samsa woke from troubled dreams.
His room, a proper human room although a little too small.
Medical Skills
-
Scientific Skills
-
Patient Care Skills
-
Communication Skills
Language Skills
-
English
-
French
-
Spanish
My Resume
Working History
College Medical Center - Long Beach
2010 - PresentExpenses as material breeding insisted building to in. Continual so distrusts pronounce by unwilling listening. Thing do taste on we manor.
Beverly Hospital - Montebello
2008 - 2010So insisted received is occasion advanced honoured. Among ready to which up. Attacks smiling and may out assured moments man nothing outward.
Coast Plaza Hospital - Norwalk
2005 - 2008Excited him now natural saw passage offices you minuter. At by asked being court hopes. Farther so friends am to detract.
Education History
Abc University of Los Angeles
2004 - 2009Expenses as material breeding insisted building to in. Continual so distrusts pronounce by unwilling listening. Thing do taste on we manor.
Michigan State University
2003 - 2004So insisted received is occasion advanced honoured. Among ready to which up. Attacks smiling and may out assured moments man nothing outward.
Abc High School
2000 - 2003Excited him now natural saw passage offices you minuter. At by asked being court hopes. Farther so friends am to detract.
Testimonials

Our logo and business card design look great. Thanks Henry

Henry is a very creative and talented designer. I do not hesitate to work again.

Great designer! he finished our work wonderfully and just in time. thanks for everything.

Our logo and business card design look great. Thanks Henry

Henry is a very creative and talented designer. I do not hesitate to work again.

Great designer! he finished our work wonderfully and just in time. thanks for everything.

Our logo and business card design look great. Thanks Henry

Henry is a very creative and talented designer. I do not hesitate to work again.
Clients




Portfolio
Blog Posts
Contact Form
Contact Informations
- Address: 107727 Santa Monica Boulevard Los Angeles
- Phone: +38 012-3456-7890
- Job: Freelancer
- E-mail: chris@domain.com
- Skype: chrisjohnson85

Great designer! he finished our work wonderfully and just in time. thanks for everything.